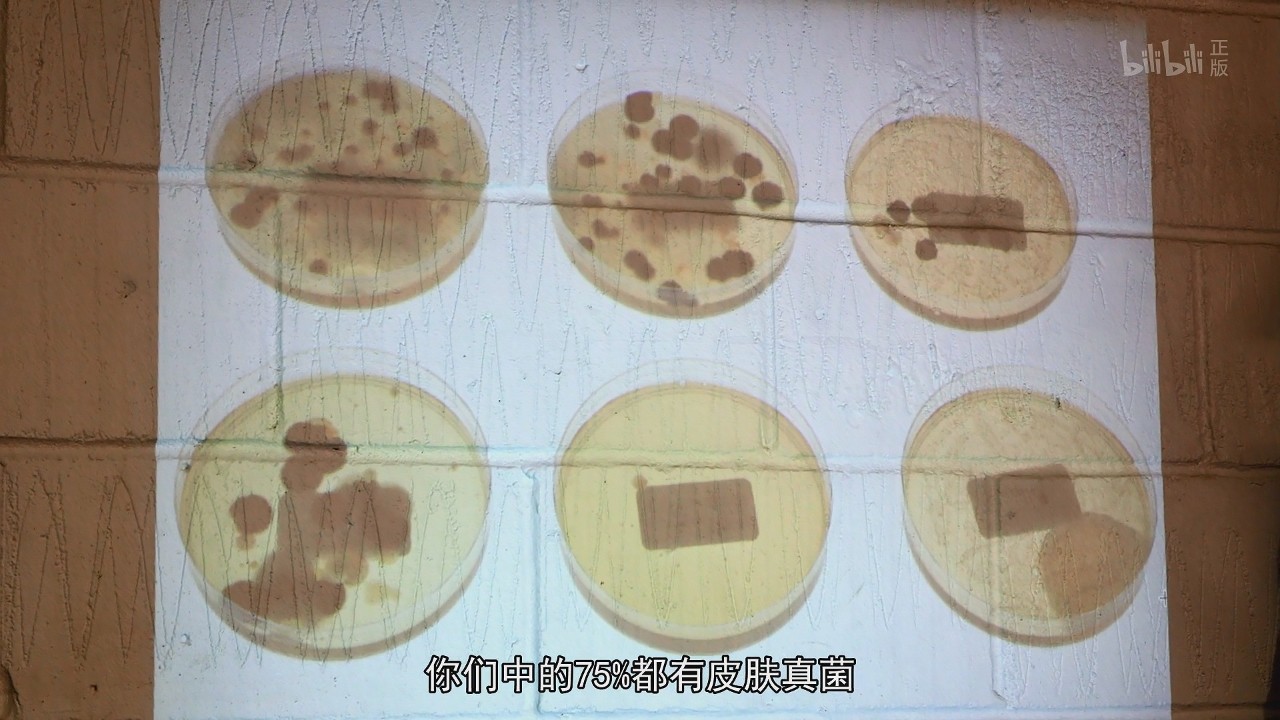
你知道药店里那些花里胡哨的药品，它们的宣传是真的吗？

药品是个大生意,全世界都不例外。不过医生开给你处方药和你到药店里凭喜好购买的非处方药完全是两个世界。
在我们国家,医生开的处方药可以说朴实到极致,有些甚至只用纸袋包装,上面潦草地标注了服用说明。而如果你很不幸要经常去药店的话,肯定会发现那些包装最酷最炫最显眼的肯定是非处方药,就好像在呼唤:“买我啊,我疗效最好!”

同样的情况在西方国家也有,英国非处方药一年的消费额高达25亿英镑,那么这些不需要医生许可就能随意购买的药品会不会只是个忽悠?
医生出身的英国人克里斯也非常好奇这个问题,于是他作为主持人拍了一部《药箱里的真相》,也就是我今天要推荐给大家的纪录片。

这部纪录片的逻辑其实很朴实,克里斯按照英国全年非处方药消费量排名来逐一分析。
止痛药
就算你不经常去药店,也一定买过布洛芬这类止痛药。疼痛可能是日常生活中最常见的症状,尤其是对于某些女性,每个月都要痛上一两天,止痛药可能是居家必备。
其实不止是在英国,欧美的止痛药市场都非常大,你可以在药店里发现一整货架不同种类的止痛药。它们有的宣传可以治头痛,有的说是治肌肉痛,还有专门治痛经的。

那么这些药是不是真的能够对不同的部位起效吗?
主持人克里斯为了验证还搞了一个高科技的胶囊摄像机,追踪口服止痛药下肚之后的去向。
显然,想想就知道,这些止痛药都是在肠道里被吸收,其中的有效成分进入身体的血液循环系统,不管是头还是脚,每个部位的药物含量都是相同的,对于一类疼痛都是有效的,而且不分部位。

商家之所以给同一种药物安上各种针对部位的宣传完全是为了细分抢占市场。这就导致消费者以为对症下药买来三种止痛药,完全不知道其实都是一样的,甚至有可能同时服用3倍剂量。
还有一类外用的止痛药膏,主要针对的是肌肉疼痛,分类上主要是冰火两重天。一种宣传温热感缓解疼痛,另一种则宣传冰凉感。

到底是热敷更能缓解肌肉酸痛还是冷敷更有效呢?
克里斯又做了一个实验,这次他来到一项5英里越野跑找了一些志愿者,将他们分成三组,一组在完成比赛后泡热水15分钟,一组泡冷水15分钟,剩下一组什么都不做。
结果显示,不管是冷热,在处理当时就能让酸痛感减轻,72小时后疼痛感减轻的幅度比不做处理的对照组要好上很多,但是冷热两组几乎效果一样。

不过道理是这个道理,但是那些宣传通过冰凉和温热来减轻肌肉疼痛的药膏和实验还并不一样。它们实际上只能产生冰凉和温热的感觉,对皮下的肌肉温度根本没有改变,尽管在包装上它们疯狂暗示深层直达肌肉。
这些止痛膏仅仅是通过感官上的刺激来转移注意力,达到暂时缓解肌肉疼痛的作用而已,至于冰还是火,看个人喜好就好。
胃药
在各种疼痛之外还有一种非常恼人的症状,那就是消化问题,包括胀气、反酸等等。可能不如疼痛来得那么猛烈,但是也称得上难缠。
于是克里斯又找来了四位志愿者,并且亲自下厨做了一顿饭请他们吃,然后让他们来评价几种不同的食物引起消化不良的可能。

志愿者普遍认为酸的食物容易引起胃酸,辣的食物也容易导致胃部不适,然而真正的元凶反而是那些看起来温和无刺激的高热量食物。
对常规的消化不良问题,最常见的治疗胃酸过多的非处方药一般都是能与胃酸反应,但是也有一种主要成分是海藻酸盐的非处方药,治疗反酸有奇效,原理是与胃酸反应形成致密的泡沫,封住胃液上窜的通路。

止咳水
咳嗽也是一个不胜其烦的毛病,咳起来没完没了,换了谁都想要一瓶灵丹妙药立即止咳。
我们都知道有很多特效止咳药都含有一些令人成瘾的成分,不仅仅是需要医生开具的处方,监管上也更加严格。
那这些非处方药能有效吗?这需要了解咳嗽的原因。导致咳嗽的原因有非常多种,比如病毒感染、炎症、化学刺激等等。

如果要根治当然就是要解决那些根源,可是只从药店随便买一瓶非处方的止咳药,真的能有效吗?
所说因素有很多,但是它们其实都是通过刺激咽喉而引起的,所以理论上只要隔绝刺激,咳嗽就能止住。所以非处方咳嗽药也都是靠在喉咙形成保护膜来达到止咳的效果,的确是有效的。
然而,这种止咳的效果实现起来非常简单,以至于我们在家里用蜂蜜柠檬调成糖浆就可以,效果几乎和止咳糖浆一样,而且更加健康。

克里斯在喝下了自己调制的蜂蜜柠檬水之后,大吸了一口胡椒喷雾,结果并没有出现之前的剧烈咳嗽,甚至没有一丝波澜。
所以如果只是普通的咳嗽,可以尝试用蜂蜜或者糖浆来止咳,至于那些含有其他药用成分的止咳水,还是建议咨询医生来选购。
脚气药膏
脚气也是一大难言之隐,几乎所有人都忌惮它的威名,以至于很多人不愿意使用公共的拖鞋。
为了了解脚气的威力,克里斯来到了一支女子足球队的更衣室与队员们畅聊一番。聊天中就有队员承认自己患有脚气,也抱怨自己很注意足部卫生,但是无奈脚汗太多。


随后克里斯用棉签采集各位队员的脚部样本,回到实验室里做进一步的培养。结果要比看起来的糟糕,有75%的队员脚上都感染了皮肤真菌。
进一步的实验也证实了,市面上售卖的非处方脚气药膏对这些真菌的生长的确有显著的抑制作用。

但是,药膏需要坚持使用才能有效果,而且并不能保证不复发。因为这些真菌真的无处不在,即便一天洗10次脚也还是有可能接触到它们。
我们应该让我们的脚变成不适合真菌生存的地方,避免湿润、高温、不透气,而不是感染后再亡羊补牢地使用药膏。
其实,客观来讲非处方药的确很大程度地方便了我们的生活,平常有个头疼脑热也可以自行购买药品缓解症状。

但是也正因为不需要处方的特点,让非处方药变成了一个巨大的市场,鱼龙混杂。有的商家把廉价的药品包装成高端商品,赚取巨额利益,有的为了销量夸大宣传,有的把概念玩出了花。
我也承认,不会有多少人会关注某种药的成分究竟是什么,到底是缓解症状还是从根源治疗。所以这样一部《药箱里的真相》就显得非常有意义了。

我在这里介绍的只是纪录片里的部分内容,如果你关心这些药品里究竟有没有猫腻,不妨亲自观看。
当然我更建议你了解一些常用药品的有效成分,这样你去药店买药的时候就可以大声地说 “给我拿一盒对乙酰氨基酚!”而不是“我想买感冒药……”彻底告别药店推销,亲测有效。